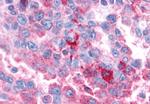
VIPR1 Antibody in Immunohistochemistry (Paraffin) (IHC (P))
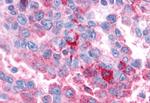
VIPR1 Antibody in Immunohistochemistry (Paraffin) (IHC (P))

Search
Invitrogen
VIPR1 Polyclonal Antibody
{{$productOrderCtrl.translations['antibody.pdp.commerceCard.promotion.promotions']}}
{{$productOrderCtrl.translations['antibody.pdp.commerceCard.promotion.viewpromo']}}
{{$productOrderCtrl.translations['antibody.pdp.commerceCard.promotion.promocode']}}: {{promo.promoCode}} {{promo.promoTitle}} {{promo.promoDescription}}. {{$productOrderCtrl.translations['antibody.pdp.commerceCard.promotion.learnmore']}}
产品信息
PA5-34303
种属反应
宿主/亚型
分类
类型
抗原
偶联物
形式
浓度
规格
纯化类型
保存液
内含物
保存条件
运输条件
RRID
产品详细信息
Percent identity with other species by BLAST analysis: Human, Gorilla, Gibbon (100%) Monkey (94%) Marmoset, Dog, Bovine, Panda, Pig (81%).
靶标信息
The Vasoactive Intestinal Polypeptide Receptor 1 (VPAC1) is a member of a family of three G-protein coupled receptors which mediate VIP (vasoactive intestinal peptide) and PACAP (pituitary adenlyate cyclase activating peptide) function in a variety of tissues. Together, the VPAC1 and VPAC2 receptors compose a subtype of the VIP receptor. Expression of the VIP and PACAP receptors has been linked to the presence of human tumors.
仅用于科研。不用于诊断过程。未经明确授权不得转售。
篇参考文献 (0)
生物信息学
蛋白别名: Pacap receptor; PACAP type II receptor; pituitary adenylate cyclase activating polypeptide receptor, type II; Pituitary adenylate cyclase-activating polypeptide type II receptor; Pvr2; type 1 vasoactive intestinal peptide receptor; unnamed protein product; Vasoactive intestinal polypeptide receptor 1; VIP and PACAP receptor 1; VIP receptor 1; VIP receptor, type I; VIP-R-1; VIP1 receptor; VIPR1; VPAC1 receptor; VPAC1R
基因别名: HVR1; II; PACAP-R-2; PACAP-R2; RDC1; V1RG; VAPC1; VIP-R-1; VIPR; VIPR1; VIRG; VPAC1; VPAC1R; VPCAP1R
UniProt ID: (Human) P32241
Entrez Gene ID: (Human) 7433